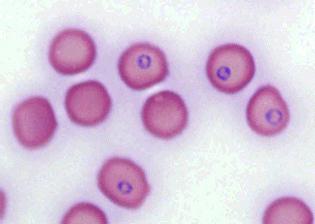

Если хозяин кошки заметил, что его питомец страдает от нескольких заболеваний одновременно, например, у него пневмония, артрит и конъюнктивит, возможно, в организм домашнего любимца попала бактерия микоплазма. Она вызывает поражения дыхательных путей и слизистых оболочек. Чаще всего хозяина настораживают отекшие и слезящиеся глаза у животного, а также постоянное чихание. Микоплазмоз у кошек – это довольно серьезное заболевание, поэтому визит к врачу откладывать не стоит.
Необходимо понимать, что вылечить эту болезнь полностью невозможно, некоторые инфекционные клетки остаются. При неблагоприятных условиях микоплазмоз может повториться вновь. Но останавливать развитие болезни нужно сразу же, не теряя времени, иначе питомец может умереть. Если хозяева подозревают микоплазмоз у кошек, симптомы, лечение не стоит определять самостоятельно. Животные обязательно нуждаются в осмотре специалиста. Иногда может потребоваться госпитализация питомца и круглосуточное наблюдение за ним.
Симптоматика
Проявляться микоплазмоз у кошек может в виде болезней мочеполовой системы. В этом случае нередки такие заболевания, как эндометрит, баланопостит или уретрит. Животное, как правило, отказывается от воды и еды и практически не двигается. Иногда болезнь поражает вначале только один глаз, а затем переходит на второй. После этого страдает носоглотка, и в тяжелых случаях – легкие. Инкубационный период заболевания составляет от трех дней до пяти недель.

Диагноз ставится на основании полного обследования, также принимаются во внимание клинические признаки. Самый достоверный способ – это провести исследование ПЦР.
Вакцин от микоплазмы не существует, поэтому полностью уберечь животное от заболевания очень сложно.
Как проявляется болезнь?
Микоплазмоз у кошек на ранних стадиях проявляется по-разному, но чаще всего присутствуют такие симптомы:
- Кашель и выделения из носа.
- Диарея.
- Лихорадка.
- Неприятные ощущения в области ребер. Кошка может чесать эту часть тела и вылизывать.
- Отеки.
- Чихание и насморк.
Как правило, врач может диагностировать помимо микоплазмоза и другие заболевания: хламидиоз, глисты, грипп или ринотрахеит.

Что должен знать хозяин питомца?
Микоплазмоз у кошек иногда передается воздушно-капельным и половым путем, а также через предметы общего пользования. Животное может заразиться внутриутробно и в натальном периоде.
Когда кошке поставлен точный диагноз, ее нужно срочно отселить от других животных, так как при контакте они могут заразиться. Человек может не опасаться за свое здоровье, для него эта бактерия не опасна.
Во время лечения, а также некоторый период после него необходимо давать кошке препараты, которые повышают иммунитет. Это обусловлено тем, что бактерии данного вида делают организм уязвимым, поэтому могут возникнуть другие заболевания. Антибиотики негативно влияют на здоровье животного и, чтобы снизить их влияние, ветеринар должен прописать питомцу специальные препараты.
Кошки, перенесшие заболевания, могут страдать бесплодием, выкидышами и родить больное, нежизнеспособное потомство. Самую большую опасность эта бактерия представляет в период беременности и родов. Но рано или поздно, болезнь начнет проявлять себя агрессивно, поэтому игнорировать микоплазмоз у кошек, симптомы которого еще очень слабы, все равно не стоит.

Как лечить питомца?
Специалисты выделяют у кошек две группы микоплазмов: M. Felis и M. Gatae. Патогенной считается первая группа, но обе могут сопровождаться другими инфекциями, например герпесвирусами или хламидиями.
Поставить окончательный диагноз и провести лечение микоплазмоза у кошек может только ветеринар, заниматься самолечением не стоит. Но для тех случаев, когда по каким-то причинам посетить врача немедленно не получается, стоит знать эффективные схемы лечения на основе антибиотиков.
Чтобы снизить негативное влияние антибиотиков на организм кошки, нужно давать ей лекарства, нормализующие работу печени, ЖКТ и обменные процессы.

Заболевание у собак
Микоплазмоз у собак – далеко не редкость. У них выделяют группу бактерий M. Cynos. Во внешней среде они не очень активны и для человека не представляют опасности. Микоплазмы входят в состав постоянной флоры, а инфекцию вызывают в том случае, когда организм ослаблен. Часто заболевание сопровождается фиброзным экссудатом.
Собаки могут страдать урогенитальными болезнями. Передача бактерий происходит воздушно-капельным путем или половым. Если плод заражен, щенок может родиться с различными патологиями и недоразвитиями. К тому же наблюдается высокая смертность в первые дни после рождения.
Микоплазмоз у собак может поражать дыхательные пути и суставы. Также для этого заболевания характерны конъюнктивиты. Собака мало двигается, конечности опухают, из носа и глаз выделяется слизь. Животное испытывает общее недомогание и лихорадку. Микоплазма может привести к болезням бронхов и пневмонии.
Гемотрофический микоплазмоз
Такое заболевание возникает тогда, когда красные кровяные клетки поражаются микоплазмой Haemocanis. Болезнь может не иметь ярко выраженных симптомов, иногда собаку беспокоит тяжелая анемия. Хозяину стоит обеспокоиться, если питомец ничего не ест, вялый, а окрас десен побледнел или приобрел бледно фиолетовый оттенок.
Где можно заразиться?
Микоплазма может попасть в организм при укусах насекомых, которые питались зараженной кровью. Также опасны драки между животными, которые сопровождаются ранениями. Иногда бактерия передается при переливании крови. Если наблюдается микоплазмоз у собак, симптомы нужно рассматривать в комплексе и сообщить о них ветеринару. Так ему проще будет назначить лечение.
Профилактические меры
Велик риск заражения в том случае, когда питомец живет на улице или много времени там проводит. Поэтому ему нужно уделять достаточно внимания, чтобы не пропустить болезнь. В запущенной стадии поражаются все дыхательные пути, что может вызвать остановку сердца. Если начать терапию вовремя, лечение микоплазмоза у кошек даст хороший результат.
В качестве профилактики заболевания необходимо обеспечить питомцу правильное и сбалансированное питание, вовремя проводить вакцинации и не пропускать осмотры у ветеринара.
Режим дня и уход
Через неделю после того, как был поставлен диагноз, животное должен осмотреть ветеринар и взять необходимые анализы, чтобы точно определить его состояние. Стоит помнить, что питомец, который был инфицирован, даже после лечения становится переносчиком инфекции. Проводить случку нельзя до тех пор, пока ветеринар не разрешит. Нужно позаботиться о том, чтобы рацион собаки был полноценный, и она получала все необходимые компоненты.
Микоплазмоз кошек вызван простейшими микроорганизмами: M.Gateae, M.Felis и M.Feliminutum. Болезнь контагиозной природы, поражающая системы организма. Например, может развиться двухсторонний конъюнктивит, который затрагивает 3-е веко, выявляют также нарушения работы дыхательной, мочеполовой и опорно-двигательных функций.
Болезнь редко начинается самостоятельно. Чаще она протекает на фоне другой патологии или при сильном снижении иммунитета животного. Заболеть кошка может в любом возрасте. При неправильном или несвоевременном лечении, болезнь может спровоцировать серьезные осложнения в организме. А также микоплазмоз переходит в хроническую форму. Недуг может стать причиной пневмонии или привести к отеку легких.
Важно! Патология иногда протекает бессимптомно.
Источник инфекции
Микоплазмы находятся везде: в почве, в воде, на растениях, предметах обихода, ее можно даже принести на одежде и обуви. Но возбудитель неустойчив во внешней среде и быстро погибает.
Инкубационный период длится до 10 дней. В это время инфекционный агент распространяется по организму, а также на других кошек.
Опасность грозит больше маленьким котятам и кошкам в возрасте до 2 лет.
Питомец может заболеть только при контакте с больным животным или с носителем инфекции. Во время родов есть риск передачи микоплазмов котятам, возможно внутриутробное заражение. А также животное может заразиться через предметы ухода за больной кошкой: игрушки, подстилку, миску и все вещи, которых касалось нездоровое животное.
Проникая в организм, возбудитель проходит в клеточные структуры слизистых оболочек, конъюнктивы, респираторной и мочеполовой системы. Также могут обитать в суставах. Живя в организме животного, микроорганизм выделяет эндотоксин, который порождает различные нарушения в организме.
М.Gatae редко является причиной каких-либо серьезных нарушений в организме. Этот вид возбудителя встречается в слизистой верхних дыхательных путей. При развитии патологии, в случае низкого иммунитета или на почве другой патологии, могут быть конъюнктивиты, пневмонии, болезни системы мочеполовых органов. Редко аборты и полиартриты фиброзно-гнойного характера.
М.Felis представляет большую опасность для здоровья кошки. Здесь уже можно увидеть полную клиническую картину болезни.
Важно! Микоплазмы, находясь в организме, выделяют особые вещества. Они позволяют патологии протекать незаметно для иммунной системы питомца.
Симптомы микоплазмоза
Если болезнь никак не проявляет себя, то хозяин должен насторожиться при таких признаках:
Клиническая картина:
- вялость;
- кашель и чихание;
- ринит;
- выделения из носа и глаз, серозного или катарального характера;
- нарастающая интоксикация организма;
- отечность и покраснение конъюнктивы;
- увеличение лимфоузлов;
- цистит;
- рвота;
- диарея;
- запор;
- затрудненное мочеиспускание или самопроизвольное мочеиспускание.
- выкидыш или рождение мёртвого потомства;
- отечность суставов;
- повышение температуры тела.
Важно! Запущенная форма болезни и отсутствие должного лечения могут привести к смерти питомца.
Хроническая форма протекает не так явственно, как острая. При рецидиве микоплазмоза хронической формы наблюдается легкое слезотечение и насморк. Поэтому, если ваш кот периодически “простывает”, вам следует обратиться в ветклинику и исследоваться на наличие микоплазмов в организме питомца.
Недуг может спровоцировать бесплодие или же рождение мертвых котят. Если же они остались живыми при родах, то они будут заражены микоплазмозом и могут иметь множественные патологии.
Осложнения
При своевременном и правильном лечении, последствий можно избежать. Если кошка сильно болеет или патология протекает на фоне интенсивного снижения иммунитета, то могут развиться осложнения:
- болезни сердца: аритмия или тахикардия, перикардит;
- артриты или артрозы;
- гепатиты или гепатозы;
- почечная недостаточность, нефросклероз.
Диагностика и лечение
Диагноз на микоплазмоз ставят комплексно: собирают анамнез, данные осмотра животного, проводят анализ биологических жидкостей, например, смыв с конъюнктивы или выделения из половых органов. Для того чтобы дифференцировать патологию от других со схожими симптомами – проводят исследования ИФА и ПЦР. А также собирают кровь для биохимического анализа.
Для успешного лечения патологии, важно соблюдать его схему:
- Антибиотикотерапия. Продолжительность зависит от выбранного препарата и состояния кошки. В основном от 7 до 14 дней. Здесь применяются антибиотики тетрациклинового ряда.
- Симптоматическая терапия. При поражении глаз или носовых ходов — специальные капли, промывание слизистых оболочек физрастворами. Лечить до устранения симптомов.
- Иммуномодулирующая терапия. Для ослабленных животных. Курс до 5 дней.
- Поддерживающая терапия. Так как кошка принимает антибиотики нужно позаботиться о состоянии печени. Поэтому назначают средства поддерживающие её функции. А также стоит учитывать, что при терапии антимикробными препаратами, страдает микрофлора кишечника. Назначают медикаменты, в состав которых входят полезные бактерии для ЖКТ. Время лечения такое же, как и курс антибиотиков.
Лечение может проходить в домашних условиях. Только после консультации ветеринарного врача и при тщательном выполнении всех рекомендаций. Госпитализации подлежат кошки, которые находятся в тяжёлом состоянии.
При назначении лечения, нужно учитывать и сопутствующие заболевания. Например, если у питомца есть поражения печени, то об этом следует сказать ветеринару.
Перед тем как начать лечение рекомендуется сделать тест на чувствительность к антибиотикам.
При острой форме болезни от симптомов можно избавиться за 3-4 дня. При хронической форме выздоровление может затянуться на несколько месяцев. После прохождения курса лечения, важно проконсультироваться у ветеринара. Это необходимо, чтобы провести исследования на наличие возбудителя в организме.
Уход за кошкой во время болезни
Если питомец живёт в квартире один, без других кошек, то его не следует изолировать в отдельное место. Достаточно организовать для него удобный и комфортный лежак. Обеспечить его свежим питьём и едой, которая не будет излишне нагружать ЖКТ и печень. Включить в рацион животному побольше витаминов и минералов.
Важно! Чтобы не доставлять питомцу лишнее страдание, его не следует брать на руки. Это связано с тем, что патология развивается также в суставах и может причинять кошке боль.
Выздоровление от инфекции зависит от многих факторов. Прежде всего — это правильный диагноз, который поставит только ветеринарный врач. Далее, надо соблюдать все его предписания и схему лечения. Давать антибиотиками нужно столько, сколько рекомендует специалист, а не прекращать их прием, когда симптомы утихли.
А также выздоровление зависит от иммунитета животного. Чем он выше, тем быстрее выздоровеет питомец. Поэтому нужно помогать поднимать резистентность организма правильным рационом питания и иммуномодуляторами.
Профилактика
Следует помнить, что микоплазмоз чаще протекает на почве других заболеваний. Поэтому стоит позаботиться о своевременной вакцинации животного. А также следует наблюдать за иммунитетом питомца, и периодически пропивать курс витаминов и минералов.
Стоит ограничить контакт с другими кошками, особенно с теми, кто ранее перенес какие-либо заболевания или же болеет микоплазмозом. Нужно постараться создать питомцу комфортные к проживанию условия. Организовать правильное питание, чтобы оно покрывало потребность организма в микроэлементах.
Необходимо позаботиться о температуре дома, так как кошка может простыть и на фоне снижения иммунитета, у нее может развиться микоплазмоз. Место, где живет животное, должно быть, чистое и своевременно убрано, также лоток должен быть всегда чистым. Не забывайте
Для того чтобы животное не заболело, важно не подвергать ее стрессам. Создать дома комфортную атмосферу. Не кричать и не бить животное.
Опасность для человека
Хоть люди и страдают от микоплазмоза, но заразиться им от питомца невозможно. Виды, которыми могут поражаться кошки, не опасны для человека. Все же, если кошка болеет, не следует пренебрегать мерами личной гигиены и после общения с животным, тщательно мыть руки. А также следует уменьшить контакты болеющих людей и детей.
В крайне редких случаях микоплазмы от кошки находят у человека с угнетенной иммунной системой.
Если в вашем доме живет несколько кошек, то следует ввести карантин для больного животного. Не стоит беспокоиться в случае, если у вас есть иные домашние питомцы (собаки, кролики, попугаи и т.д.), так как кошачьи возбудители микоплазмоза им не передаются.
Полезное видео
Ветеринар о микоплазмозе у кошек:
Чтобы ограничить своего питомца от микоплазмоза, важно окружить его заботой и вниманием. Не игнорировать прививки. Помнить, что патология возникает на почве сниженного иммунитета и других заболеваний, поэтому обеспечить его питанием, которое бы покрыло потребности в витаминах и минералах. Создать такие условия, чтобы животное поменьше контактировало с уличными кошками или больными.
При обнаружении даже незначительных клинических признаках — срочно обратиться за помощью. При лечении важно строго соблюдать все рекомендации врача. И тогда ваше животное будет здорово и счастливо.
Взяв в дом питомца, хозяин с этого момента берет на себя всю ответственность за его здоровье. Речь в статье пойдет о такой проблеме, как микоплазмоз у кошек. Данное заболевание может атаковать животное, даже если владелец окружил его любовью, заботой и создал все необходимые условия жизни. По какой же причине тогда может случиться микоплазмоз у кота, какие симптомы и способы лечения данной болезни?
Какие животные находятся в группе риска?
Относится микоплазмоз к разряду инфекционных заболеваний, которое довольно широко распространено среди пушистых домашних любимчиков. Виновниками его возникновения являются бактерии Mollicutes.
Самыми незащищенными перед микоплазмозом считаются маленькие котятки и бездомные представители кошачьего царства. Объясняются данные утверждения довольно просто, у этих групп животных слабый иммунитет. У малышей иммунная защита еще не окрепла, а у бездомных она слабая из-за ненадлежащих жизненных условий, да и окружающая обстановка, как будто приглашает бактерии к размножению.
К болезни приводят некоторые причины:
- Сапротрофные бактерии являются отравителями организма.
- Бактерии Микоплазма не имеют своих клеточных стенок, из-за этого вредители цепляются к клеткам в организме котиков, поглощая при этом нужные для нормальной жизнедеятельности микроэлементы.
Вредительство данных бактерий доводит организм до потери сил, в конце концов, кошка совершенно ослабевает. Такое печальное состояние сопровождают определенные симптомы.
Добравшись до организма живого существа, бактерии могут не сразу обнаружить там идеальную среду размножения. В таком случае эти вредители тихонько сидят и ждут подходящего момента для активизации, устраивая для себя так называемое время сна. Это очень опасно, так как лечение может начаться не вовремя, и микоплазмоз у кошек приобретет хроническую форму.
Самыми первыми признаками, которые сигнализируют о том, что пора лечить кошку, считаются следующие: кашель, насморк, воспаление.
Образовывается пленка на глазах. Ринит. Кровоточащие ранки. Вокруг глаз появляются довольно заметные корочки с гнойными выделениями. Пневмония. У беременных кошек самопроизвольные аборты.
Кроме вышеперечисленных симптомов микоплазмоз может неблагоприятно повлиять на мочеполовую систему, в итоге появляется цистит, бесплодие, уретрит. Также бывают случаи, когда разрушается костная ткань и суставы, кошка страдает от артрита.
Важность правильной диагностики
Внимательный владелец питомца в домашних условиях способен только заподозрить наявность заболевания под названием микоплазмоз. Точный диагноз самостоятельно без помощи работников ветеринарной лаборатории и без осмотра ветеринарного врача поставить невозможно. Из этого следует, что заметив у котика симптомы, указывающие на наличие инфекции нужно срочнейшим образом показать любимца специалисту.
В условиях лаборатории для диагностики микоплазмоза проводится бактериологический анализ, который покажет, есть ли в организме животного паразиты. Если бактерии действительно уже заняты своим черным делом, опытный ветеринарный врач назначит комплексное лечение, состоящее из применения нескольких эффективных средств. Подобные медикаменты способны полностью избавить питомца от вредителей. Услуги по диагностике и лечению котов оказывает наш ветеринарный центр скорой помощи.
Определившись с диагнозом, необходимо срочно приступать к спасению домашнего любимца. Существует определенная схема правильного лечения. Назначить подходящий курс должен ветеринарный врач.
Микоплазмоз у кошек имеет схему лечения несложную, главное, придерживаться всех пунктов:
- Антибиотики, способные ослабить активность инфекционных бактерий.
- Препараты, поддерживающие работу внутренних органов.
- Препараты иммуномодулирующие, благодаря ним организм способен сопротивляться инфекциям, вредным бактериям.
- Обработка слизистых оболочек препаратами с тетрациклином.
Если соблюдать все рекомендации и выполнять все процедуры, которые способны снимать воспалительные процессы, состояние домашнего питомца очень скоро облегчится. В большинстве случаев курс приносит положительные результаты по истечении 1.5-2 недель, при этом первое облегчение наступает через несколько дней после начала приема медикаментов. Уже спустя 3 недели болезнь полностью отступает, кошка возвращается к здоровой жизни.
Наука определила около 20 разных видов вредоносных бактерий, которые могут вызвать микоплазмоз. Увидев неприятные симптомы, проявившиеся на кошке, владелец опасается, что сам может заразиться подобной болезнью, но опасаться в данных случаях не нужно.
У представителей кошачьего мира наблюдаются только 2 вида паразитов, вызывающих микоплазмоз у кошек — Mycoplasma gatae и Mycoplasma felis. Данные вредители не опасны для людей, держатель заболевшего котика не сможет заразиться от него подобной болезнью.
Профилактические действия
Каждый владелец кота должен знать, что такие питомцы каждый день подвергаются риску заболеть микоплазмозом.
Не допускать контактов домашних котиков с их бездомными сородичами. Полноценное, сбалансированное питание. Обеспечить нужное количество витаминных добавок. Включить в рацион иммуномодуляторы. Вовремя реагировать на симптомы, указывающие на заболевания. Регулярные профилактические осмотры у ветеринарного врача. Неукоснительное выполнение предписаний ветеринарного врача. Питание, внимание и уход. Правильно поставленный диагноз. Индивидуально назначенный курс лечения. Сила иммунной защиты животного.
Вакцины, предохраняющей от микоплазмоза, пока что не изобретено. Это совсем не повод отчаиваться и паниковать. Правильный уход и внимательное отношение поможет справиться с заболеванием медикаментозно. Эффективность курса лечения и скорейшее выздоровление зависит от многих факторов:
За здоровьем тех, кого приручили нужно следить внимательно, любить их и защищать. Своевременная плановая вакцинация необходима, она обезопасит питомцев от болезней, которые ослабляют иммунитет. Очень важно быстро реагировать на симптомы и решать проблемы со здоровьем животного с помощью ветеринарного специалиста. В нашем центре ветеринарной скорой помощи можно получить бесплатную консультацию, а затем и квалифицированную помощь ветеринарных врачей с большим опытом работы.
Микоплазмоз у кошек относится к категории инфекционных заболеваний, возбудителем которых являются простейшие микроорганизмы M. gatae и M. felis.
После проникновения в организм животного они быстро адаптируются в нем, поражая практически все внутренние органы дыхательной и мочеполовой системы, суставы и костные ткани.
Проявляется болезнь смазанными симптомами, которые трудно обнаружить на начальных стадиях ее развития. А прогрессирование патологии влечет за собой серьезные последствия, вплоть до летального исхода.
Описание микоплазмоза
Возбудители микоплазмоза у кошек относятся к разряду факультативных аэробных паразитов, занимающих промежуточное место между грибками, бактериями и вирусами.
Их главная особенность заключается в том, что они обладают способностью видоизменять свою форму, так как не имеют клеточных стенок, что существенно усложняет процесс диагностики болезни.
M. gatae и M. felis способны выживать вне живого организма на протяжении некоторого времени.
Однако при возникновении неблагоприятных условий (низких температур, высокого уровня УФ, воздействия хлорсодержащих средств и т. д.) быстро погибают.
Но несмотря на это, они проявляют высокую стойкость по отношению к некоторым антибактериальным препаратам. В основном обитают на поверхностях грунта, растениях, предметах обихода и в воде.
Имеют несколько путей передачи:
- воздушно-капельный;
- контактный (во время игр, драк и т. д.);
- половой;
- во время беременности и родовой деятельности (от зараженной кошки к потомству);
- при переливании крови.
Проникая в организм животного, микоплазмы начинают активно выделять эндотоксины, которые провоцируют активацию деструктивно-дегенеративных процессов в тканях, что впоследствии приводит к их разрушению и нарушению их функциональности.
Симптомы микоплазмоза у кошек
Микоплазмоз у кошек выраженных симптомов не имеет.
Проявляется он различными клиническими признаками, которые носят смазанный характер, например:
- ухудшение аппетита и уменьшение массы тела;
- воспаление конъюнктивы;
- снижение физической активности;
- побледнение десен;
- слизистые выделения из глаз;
- повышенное слюноотделение.
Важно! Если на этой стадии микоплазмоз у кошки будет диагностирован, симптомы купированы и лечение произведено до конца, то есть высокие шансы победить болезнь и сохранить здоровье питомца.
Когда заболевание на этой стадии не распознается, со временем клиническая картина усложняется.
Симптоматика становится выраженной и включает в себя следующие признаки:
- выпадение шерсти;
- нарушение мочеиспускания;
- расстройства пищеварения (рвота, тошнота, запоры, диарея);
- гнойные выделения из глаз.
Питомца начинают мучить болезненные ощущения в области ребер, он практически постоянно лежит и редко встает.
Гнойные выделения из носа и глаз являются характерным признаком микоплазмоза.
При поражении суставных элементов наблюдается нарушение двигательных функций животного, что отчетливо отслеживается по его походке – кошка хромает, поджимает лапки, долго не может находиться в стоячем положении.
Так как микоплазмоз кошек поражает различные внутренние органы и системы питомца, симптоматика включает в себя разные симптомы, из-за чего болезнь несложно спутать с другим заболеванием, например, простудой.
Бессимптомное протекание микоплазмоза у кошек наблюдается редко. Единственный признак, по которому определяется наличие болезни, – изменение поведения питомца.
Он становится вялым и много спит. Так проявляется резкое снижение иммунитета вследствие воздействия инфекции на организм.
Причины микоплазмоза, группа риска
В группе риска по заражению микоплазмозом находятся:
- котята в возрасте до 2 лет;
- животные с пониженным иммунитетом;
- кошки, у которых имеются хронические патологии.
Так как возбудитель данной болезни не может длительное время существовать вне живого организма, заразится им во время питья воды или при употреблении пищи практически невозможно.
Поэтому считается, что единственным способом передачи инфекции является непосредственный контакт с зараженным животным.
Проникновение микроорганизмов в организм здоровой кошки может происходить при переливании крови, при контакте с открытыми ранами или порезами, при половом акте, при родоразрешении (от матери к котенку).
Диагностика и лечение
При наличии у животного признаков микоплазмоза, его необходимо сразу же отвезти к ветеринару. После изучения анамнеза врач произведет физический осмотр кошки и назначит развернутый анализ крови.
Пневмония является частым осложнением после микоплазмоза.
В случае, если в организме питомца действительно развивается инфекция, лабораторные исследования выявляют анемию – пониженное содержание красных кровяных тел.
Вместе с этим анализом рекомендуется также сделать:
- скрининг;
- анализ проточной цитометрии (считается самым информативным методом диагностики микоплазмоза);
- анализ слизистой половых органов;
- мазок оболочки глаза.
Если в ходе диагностики диагноз подтверждается, лечение микоплазмоза у кошек осуществляют незамедлительно. Определенной схемы лечения данного заболевания нет. Здесь все зависит от выраженности клинических проявлений и общего состояния животного.
Антибактериальная терапия назначается в любом случае. Она обеспечивает подавление роста бактерий и способствует улучшению самочувствия питомца.
Выбор антибиотиков осуществляется индивидуально после проведения специального теста на восприимчивость. Если у питомца обнаруживается выраженная анемия, проводится переливание крови.
Помимо антибактериальной терапии, проводится также симптоматическое лечение, которое включает в себя прием препаратов вяжущего, обезболивающего и противорвотного действия.
Довольно часто единственным признаком микоплазмоза у кошек является слабость животного.
Также для животного в этом период будет полезным прием лекарств и биологически активных добавок, способствующих улучшению работы пищеварительной системы.
Чтобы ускорить процесс выздоровления и предотвратить развитие осложнений на фоне микоплазмоза, рекомендуется давать животному иммуномодулирующие препараты.
Важно! Если микоплазмоз у кошек проявляется выраженными симптомами, то лечение осуществляется в стационаре.
Только после того, как состояние питомца нормализуется, его отдают хозяевам, но терапия на этом не заканчивается. Дома также потребуется обеспечить животному прием всех необходимых препаратов, правильное питание и покой.
Все лекарственные препараты для лечения микоплазмы у животного, их схема приема, дозировка и длительность определяются врачом индивидуально. Однако существуют некоторые медикаменты, которые применяются практически в 90% случаях.
Доксициклин и левомицетин – антибиотики широкого спектра действия, имеющие высокую эффективность в борьбе с возбудителями микоплазмоза.
Ветеринары назначают азитромицин для поддержания иммунитета питомца
Положительные результаты от их приема наблюдаются уже на второй день. Если у животного отмечает непереносимость этих препаратов, то их заменяют на Тилозин или Байтрил.
При этом заболевании также часто назначают:
- Карсил, Катозал или Гамавит – эти средства обеспечивают стимуляцию работы внутренних органов.
- Циклоферон, Иммунофан или Риботан – действие данных препаратов направлено на укрепление иммунитета.
- Тетрациклин – обладает антибактериальным действием, применяется для обработки пораженных слизистых оболочек глаз и половых органов.
Чтобы предотвратить развитие осложнений на фоне микоплазмоза у кошки и лечение дало быстрые результаты, животному необходимо обеспечить правильный уход.
Все лекарственные препараты для лечения микоплазмы у животного, их схема приема, дозировка и длительность определяются врачом индивидуальн
Если помимо него в квартире больше нет домашних питомцев, изолировать его не нужно. Достаточно просто создать для него комфортный и удобный лежак.
Чтобы не причинять кошке лишних страданий, ее не стоит брать на руки. Связано это с тем, что при развитии микоплазмоза поражаются все суставные и костные ткани животного, и любые движения могут вызвать сильные болевые ощущения.
Важно! Купать, вычесывать и выгуливать питомца в период лечения запрещено.
На момент лечения рацион кошки должен подлежать корректировке. Если она находится на домашнем питании, нужно следить за тем, чтобы употребляемая ею пища была свежая и приготовлена из качественных продуктов.
Важно обеспечить животное обильным питьем, витаминами и минералами. Для восполнения последних можно использовать специальные витаминные комплексы для домашних питомцев. При их выборе нужно обязательно учитывать возраст и вес кошки.
Методы профилактики
Прививок от микоплазмоза не существует. Однако это не говорит о том, что предотвратить развитие этого заболевания у домашнего питомца нельзя.
В качестве профилактики микоплазмоза, врачи-ветеринары рекомендуют прививать животное от других болезней согласно плану и уделять достаточное внимание его иммунитету, обеспечивая его всеми необходимыми минералами и витаминами.
Такие мероприятия хоть и не обезопасят кошку от этого недуга, но значительно снизят риски ее заражения от других питомцев.
Представляет ли больная кошка опасность для человека?
Несет ли микоплазмоз у кошек опасность для человека, сказать сложно. По этому поводу существует два мнения. Одни утверждают, что возбудители, вызывающие болезнь у животного, не опасны для человека.
Другие, что при воздействии некоторых факторов контакт с больной кошкой может привести к серьезным последствиям.
В особенности в группе риска находятся люди с пониженным иммунитетом, болеющие вирусными и инфекционными заболеваниями, а также дети в возрасте от 0 до 3 лет.
У женщин микоплазмоз может приводить к:
- нарушению менструального цикла;
- обострению хронических патологий репродуктивных органов;
- нарушению зрения;
- суставным заболеваниям;
- нарушению работы печени и почек.
Для мужчин с ослабленным иммунитетом микоплазмоз опасен:
- нарушением потенции;
- развитием заболеваний мочеполовой системы;
- бесплодием.
Заключение
Микоплазмоз у кошек может развиваться вне зависимости от возраста и породы. Данному заболеванию подвержены все животные.
Поэтому очень важно постоянно следить за питанием кота и изолировать его от других питомцев, у которых имеются все симптомы этой болезни.
Читайте также:









